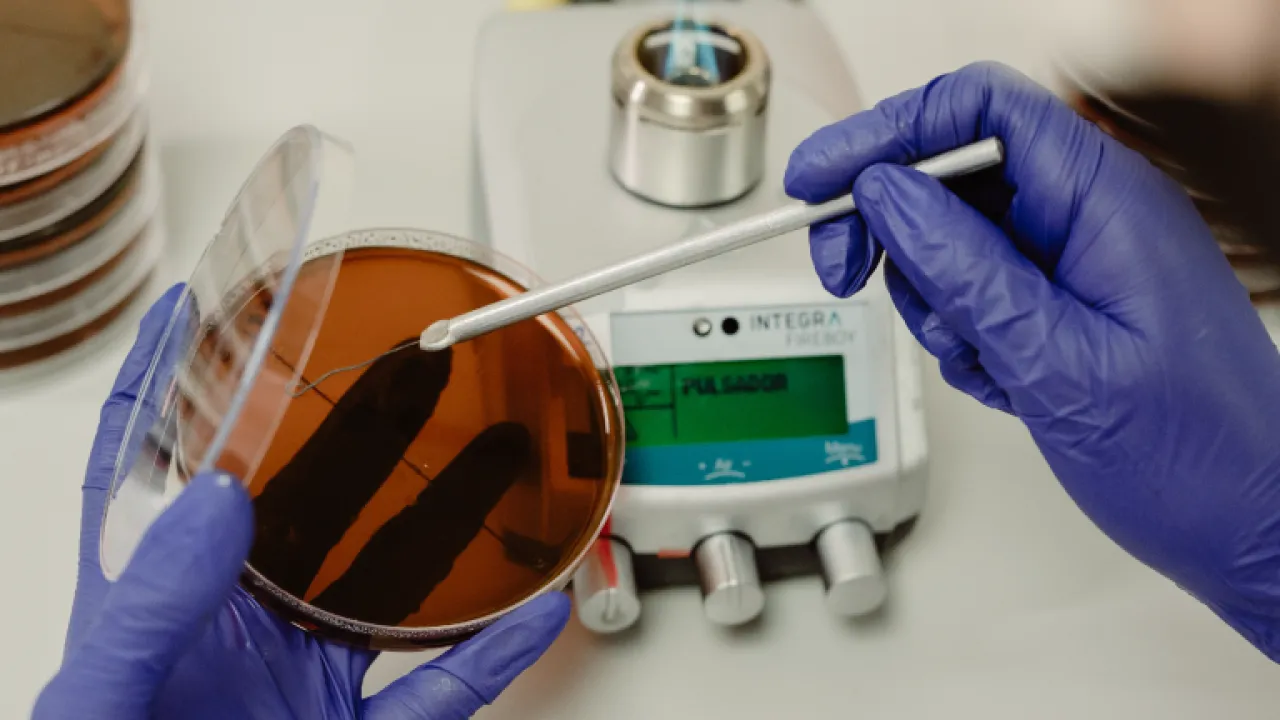
Medicina-investigaciones-biomedicas-actualmente-en-desarrollo

Facultad de Medicina
Formamos médicos líderes, con vocación y compromiso humanitario.
¡Talentos como tú merecen cumplir sus sueños! Ponemos a tu disposición un conjunto de becas que buscan explotar tu máximo potencial, para que seas parte de nuestra comunidad de apasionados por lo que hacen.
¡Excelencia Médica en la Facultad de Medicina de la UDLA!
La Facultad de Medicina te forma como un médico de excelencia, combinando una sólida base científica con práctica clínica intensiva desde los primeros semestres. Con docentes especializados y acceso a tecnología de punta, te preparamos para enfrentar los desafíos de la salud global. Únete a una comunidad comprometida con la ética y el bienestar, y lidera el cambio en la medicina.
UDLA en cifras
Proyectos de investigación biomédica en curso
Graduados pregrado
Cantidad de Hospitales con convenios
Instalaciones y Tecnología
Contamos con el Centro de Simulación Clínica más grande y avanzado del país.
Convenios con prestigiosas clínicas y hospitales del país en el ámbito público y privado.
Laboratorios de docencia con equipos reales para educación en biología, microbiología, química.

- Impacto global de las distintas enfermedades epidemiológicas en el Ecuador
- Programa de Bioquímica Informática
- Synthetic Organogenesis: Using In Vivo Cellular Reprogramming To Induce Ectopic Pancreas
- Fighting liver cancer heterogeneity and aggressiveness by inhibiting Hippo and Oxytocin Receptor signaling
- Suppressing liver cancer by cell competition
- Understanding the mechanisms of organ size normalization in overgrown livers
- Exploring small extracellular vesicles in glioblastoma under hypoxic conditions: A novel insight into tumor progression
Filosofía
Formar médicos generales competentes, éticos, empáticos, con vocación de servicio, que acepten los desafíos de una profesión en constante evolución, que respondan a las necesidades de salud de la sociedad; cuya preparación les permita avanzar hacia la educación de posgrado en sus diferentes modalidades y alcanzar cualquier meta de desarrollo profesional que se propongan dentro de un pensamiento constructivista que promueva el autoaprendizaje a perpetuidad.
Número de hospitales con los que mantenemos convenio

Privados
10

Ministerio de Salud Pública
21

IESS
7
Privados
Ministerio de Salud Pública
IESS
Bibliotecas de medicina
Bases de datos suscriptas
Bases de acceso libre
Autoridades

Médico por la Universidad Internacional del Ecuador. Máster en Docencia Universitaria y Neurociencias por King’s College London. Director y docente de Psiquiatría en la Facultad de Medicina de la UDLA.

El Dr. Wilson Chicaiza es médico familiar y magíster en Educación para Profesionales de la Salud, con amplia trayectoria en docencia, gestión académica e investigación. Ha ocupado cargos clave en el Hospital Vozandes y en la UDLA, donde actualmente es Director Académico de la Facultad de Medicina.

Médica con especialización en Medicina Familiar y maestría en Gerencia Hospitalaria. Actualmente cursa posgrados en Innovación Educativa (UDLA) y Diabetes y Obesidad (PUCE). Es Coordinadora Académica en la UDLA y cuenta con amplia experiencia docente y administrativa. Desde 2018 trabaja en el IESS El Batán en el área de crónicos metabólicos.

Médico por la Universidad Internacional del Ecuador. Máster en Docencia Universitaria y Neurociencias por King’s College London. Director y docente de Psiquiatría en la Facultad de Medicina de la UDLA.

El Dr. Wilson Chicaiza es médico familiar y magíster en Educación para Profesionales de la Salud, con amplia trayectoria en docencia, gestión académica e investigación. Ha ocupado cargos clave en el Hospital Vozandes y en la UDLA, donde actualmente es Director Académico de la Facultad de Medicina.

Médica con especialización en Medicina Familiar y maestría en Gerencia Hospitalaria. Actualmente cursa posgrados en Innovación Educativa (UDLA) y Diabetes y Obesidad (PUCE). Es Coordinadora Académica en la UDLA y cuenta con amplia experiencia docente y administrativa. Desde 2018 trabaja en el IESS El Batán en el área de crónicos metabólicos.














